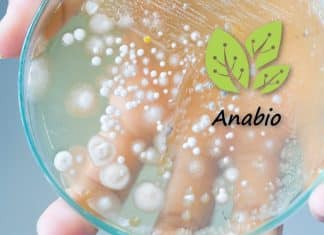
Senior Microbiologist Recruitment @ Anabio Technologies Anabio Technologies Senior Microbiologist

I-Lab : New Mobile COVID-19 Testing Lab To Expand Testing In...
New Mobile COVID-19 Testing Lab
Developed By DBT and AMTZ
To speed up the testing of suspects of COVID-19 carriers amidst ever-increasing cases of coronavirus in...
TANUVAS Research Fellow Job For Biotech / Microbiology / Zoology Candidates
TANUVAS Research Fellow Job For Biotech / Microbiology / Zoology Candidates
TANUVAS Research Fellow Job For Biotech / Microbiology / Zoology Candidates. BSc candidates are...
IISER Tirupati Life Science & Biotech Research Fellow Job Opening
IISER Tirupati Life Science & Biotech Research Fellow Job Opening
IIISER Tirupati Life Science & Biotech Research Fellow Job Opening. IISER Tirupati Job Junior Research...
Punjab Agricultural University Junior Research Fellow Recruitment
PAU Computational Biology JRF Jobs Vacancy - MSc/MTech Apply
PAU Computational Biology JRF Jobs Vacancy - MSc/MTech Apply. Junior Research Fellow Job Openings for MSc...
Central University of Gujarat Botany & Zoology Project Assistant Job
CUG Botany & Zoology Project Assistant Job
CUG Botany & Zoology Project Assistant Job. Msc Botany and Zoology candidates can apply for a Project Assistant...
JNU School of Life Sciences Research Associate Job Opening
JNU PhD Latest Jobs - Biotech/Life Science/Genetics Apply
JNU PhD Latest Jobs - Biotech/Life Science/Genetics Apply. Jawaharlal Nehru University, jobs for phd candidates. PhD Research...
Novartis Life Science Drug Development Scientific Expert Job Vacancy
Novartis Life Science Drug Development Scientific Expert Job Vacancy
Novartis Life Science Drug Development Scientific Expert Job Vacancy. Clinical Scientific Expert - I jobs for...
Syngene Bioinformatics & Computational Biology Associate Job
Syngene Bioinformatics & Computational Biology Associate Job
Syngene Bioinformatics & Computational Biology Associate Job. Syngene Bioinformatics, Computational Biology Research Associate Jobs. Check the details on...
FREE LIVE Webinar – Attend The Genetics Master Class “Careers &...
An Exclusive FREE Webinar
A Topic Nobody Talk's About & Nobody Cares About
"CAREERS" & "MARRIAGES" - GENES Matter Or JEANS?
Biotecnika Welcomes You All to Attend...
ICAR-IARI Genetics & Biotechnology Research Fellow Job Opening
ICAR-IARI Genetics & Biotech Research Recruitment - Online Interview
ICAR-IARI Genetics & Biotech Research Recruitment - Online Interview. MSc Genetics/ Biotech/ Plant Breeding & Genetics...
Researchers Provide Breakthrough Insights On Kidney Development
Key Steps In Kidney Development Identified By Researchers
According to a new study by a researcher at Massachusetts General Hospital (MGH), understanding how certain features...
COVID-19 Safety Measures for GAT-B 2020
COVID-19 Safety Measures for GAT-B 2020
Dear Biotecnikans,
Check out the latest updates regarding the safety measures being enforced for applicants attending the GAT-B 2020 exam....
Govt BCIL Life Science Job With Rs. 40,000 pm Pay For...
Govt BCIL Project Jobs - MSc Life Science Executive Vacancy
Govt BCIL Project Jobs - MSc Life Science Executive Vacancy. MSc Life Sciences candidates can...
Senior Microbiologist Recruitment @ Anabio Technologies
Anabio Technologies Senior Microbiologist Job Recruitment
Anabio Technologies Senior Microbiologist Job Recruitment. Interested and eligible applicants can check out all of the details on the...
IISc Find 29 Potential Drugs That Could Be Used Against COVID-19
29 Drugs to fight COVID-19 discovered by IISc
Scientists at the Indian Institute of Science (IISc) have discovered at least 29 drugs that can be...
COVID-19 Vaccine By UK’s Imperial College Enters Human Trials
Imperial College COVID-19 Vaccine Human Trials Initiated
Human trials of a new coronavirus vaccine developed by the Imperial College London scientists began this week.
The study...
Junior Research Fellow Position Vacant at Yenepoya (Deemed to be University)
JRF Job Opening at Yenepoya (Deemed to be University)
JRF Job Opening at Yenepoya (Deemed to be University). Junior Research Fellow Position Vacant at Yenepoya...
CSIR-IICB MTech Biotech & MSc Life Science Project JRF Recruitment
CSIR-IICB Project JRF Jobs - Biotech & Life Sciences Apply
CSIR-IICB Project JRF Jobs - Biotech & Life Sciences Apply. MSc Life Sciences & MTech...
National Health Mission Microbiology Job With Rs. 60,000 Salary pm
NHM Microbiology Job With Rs. 60,000 Salary pm
NHM Microbiology Job With Rs. 60,000 Salary pm. National Health Mission Job Openings. MSc & PhD Microbiology...
Biotecnika Times – Newsletter 19.06.2020 – Defence Food Research Job, Govt...
Biotecnika Times - Defence Food Research Job, Govt CSIR-CIMAP Online
Defence Food Research Lab – DRDO Fellowship Recruitment 2020
DRDO-DFRL Recruitment 2020 – DRDO Fellowship Microbiology...